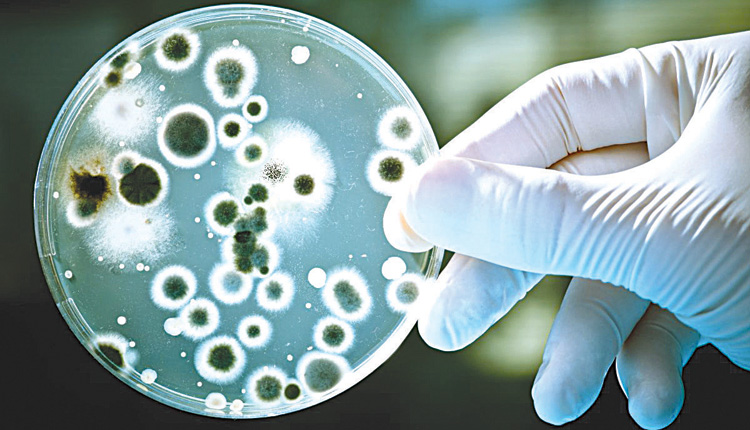

SOS από τους επιστήμονες για την αυξημένη συχνότητα των νοσοκομειακών λοιμώξεων
Η ιδιαίτερα αυξημένη συχνότητα των νοσοκομειακών λοιμώξεων που οδηγούν σε βαρύτατες νοσήσεις και θανάτους και το χαμηλό ποσοστό εμβολιαστικής κάλυψης, ανησυχούν τους επιστήμονες, οι οποίοι κρούουν τον κώδωνα του κινδύνου για άλλη μια φορά, επισημαίνοντας την ανάγκη εκπαίδευσης των γιατρών στη σωστή χρήση των νεότερων αντιβιοτικών και λήψης μέτρων για τη σημασία των εμβολίων. «Είναι τουλάχιστον απογοητευτικό να βρισκόμαστε στις πρώτες θέσεις σε συχνότητα, προβληματικών νοσοκομειακών λοιμώξεων με δραματικές συνέπειες για τη δημόσια υγεία και την εθνική οικονομία» επισήμαναν οι εκπρόσωποι της Ελληνικής Εταιρείας Λοιμώξεων με αφορμή το 19ο Πανελλήνιο Συνέδριο Λοιμώξεων που θα πραγματοποιηθεί 1-3 Μαρτίου στην Αθήνα.
Η ιδιαίτερα αυξημένη συχνότητα των νοσοκομειακών λοιμώξεων που οδηγούν σε βαρύτατες νοσήσεις και θανάτους και το χαμηλό ποσοστό εμβολιαστικής κάλυψης, ανησυχούν τους επιστήμονες, οι οποίοι κρούουν τον κώδωνα του κινδύνου για άλλη μια φορά, επισημαίνοντας την ανάγκη εκπαίδευσης των γιατρών στη σωστή χρήση των νεότερων αντιβιοτικών και λήψης μέτρων για τη σημασία των εμβολίων. «Είναι τουλάχιστον απογοητευτικό να βρισκόμαστε στις πρώτες θέσεις σε συχνότητα, προβληματικών νοσοκομειακών λοιμώξεων με δραματικές συνέπειες για τη δημόσια υγεία και την εθνική οικονομία» επισήμαναν οι εκπρόσωποι της Ελληνικής Εταιρείας Λοιμώξεων με αφορμή το 19ο Πανελλήνιο Συνέδριο Λοιμώξεων που θα πραγματοποιηθεί 1-3 Μαρτίου στην Αθήνα.
Για το πρόβλημα των νοσοκομειακών λοιμώξεων στο πλαίσιο του συνεδρίου οργανώνεται ειδικό πρόγραμμα – κλινικό φροντιστήριο για γιατρούς και νοσηλευτές με θέμα «Πρόληψη και έλεγχος των νοσοκομειακών λοιμώξεων στα ελληνικά νοσοκομεία» όπου θα συζητηθούν τα αίτια και οι τρόποι αντιμετώπισης του προβλήματος (συστηματική καταγραφή, εκπαίδευση προσωπικού, μέτρα πρόληψης, νομοθετικό πλαίσιο κ.λπ.). Επίσης, θα συζητηθούν οι ιδιαιτερότητες στην αντιμετώπιση προβληματικών λοιμώξεων από πολυανθεκτικά παθογόνα με περιορισμένες θεραπευτικές επιλογές, και η αντιμετώπιση λοιμώξεων σε ειδικούς πληθυσμούς (π.χ. σε ασθενείς με ανοσοκαταστολή).
Έμφαση θα δοθεί και στα θέματα των εμβολιασμών σε παιδιά και ενήλικες, σε συνάρτηση με την τρέχουσα επιδημία της γρίπης και την πρόσφατη επιδημία ιλαράς. «Ανησυχητικό είναι το μικρότερο από το επιθυμητό ποσοστό εμβολιαστικής κάλυψης, ακόμα και μεταξύ των εργαζομένων στην υγεία», τόνισαν οι επιστήμονες, υπογραμμίζοντας ότι είναι προτεραιότητα του συστήματος υγείας της χώρας η έγκυρη και έγκαιρη ενημέρωση των γιατρών, αλλά και των πολιτών για τη σημασία των εμβολίων.
Με σύνεση η χρησιμοποίηση των νέων αντιβιοτικών
Ιδιαίτερη σημασία θα δοθεί επίσης, στην παρουσίαση νεότερων αντιβιοτικών που κυκλοφόρησαν πρόσφατα ή πρόκειται να κυκλοφορήσουν στο αμέσως προσεχές διάστημα. Λόγω της αυξανόμενης αντοχής των μικροβίων στα διαθέσιμα αντιβιοτικά υπάρχει ανάγκη για νέα και ασφαλή φάρμακα, τόνισαν οι ειδικοί επιστήμονες, τα οποία μπορεί πραγματικά να σώσουν ασθενείς. «Αρκετά νέα αντιβιοτικά διαφορετικών ομάδων όπως νεογλυκοσίδες, συνδυασμοί β-λακταμικών με αναστολείς, άλλα β λακταμικά, τετρακυκλίνες έχουν ήδη κυκλοφορήσει και άλλα που αναμένονται σύντομα». Υπογράμμισαν όμως με έμφαση ότι θα πρέπει να χρησιμοποιηθούν με σύνεση εκεί όπου είναι πραγματικά απαραίτητα, γιατί διαφορετικά υπάρχει ο κίνδυνος να χάσουν και αυτά τη δραστικότητά τους, λόγω περαιτέρω αύξησης της μικροβιακής αντοχής.
Επιπρόσθετα θα παρουσιαστούν νεότερα δεδομένα για τη θεραπεία της πολυανθεκτικής φυματίωσης. Πρόκειται για όχι συχνό, αλλά πολύ δύσκολο στην αντιμετώπιση νόσημα με επιπτώσεις στη δημόσια υγεία, όπως είπαν οι εκπρόσωποι της Ελληνικής Εταιρείας Λοιμώξεων, το οποίο μπορεί να δημιουργήσει στο μέλλον σοβαρά προβλήματα στη χώρα ιδίως εάν δεν ενισχυθούν οι δημόσιες δομές υγείας.
ΑΠΕ














